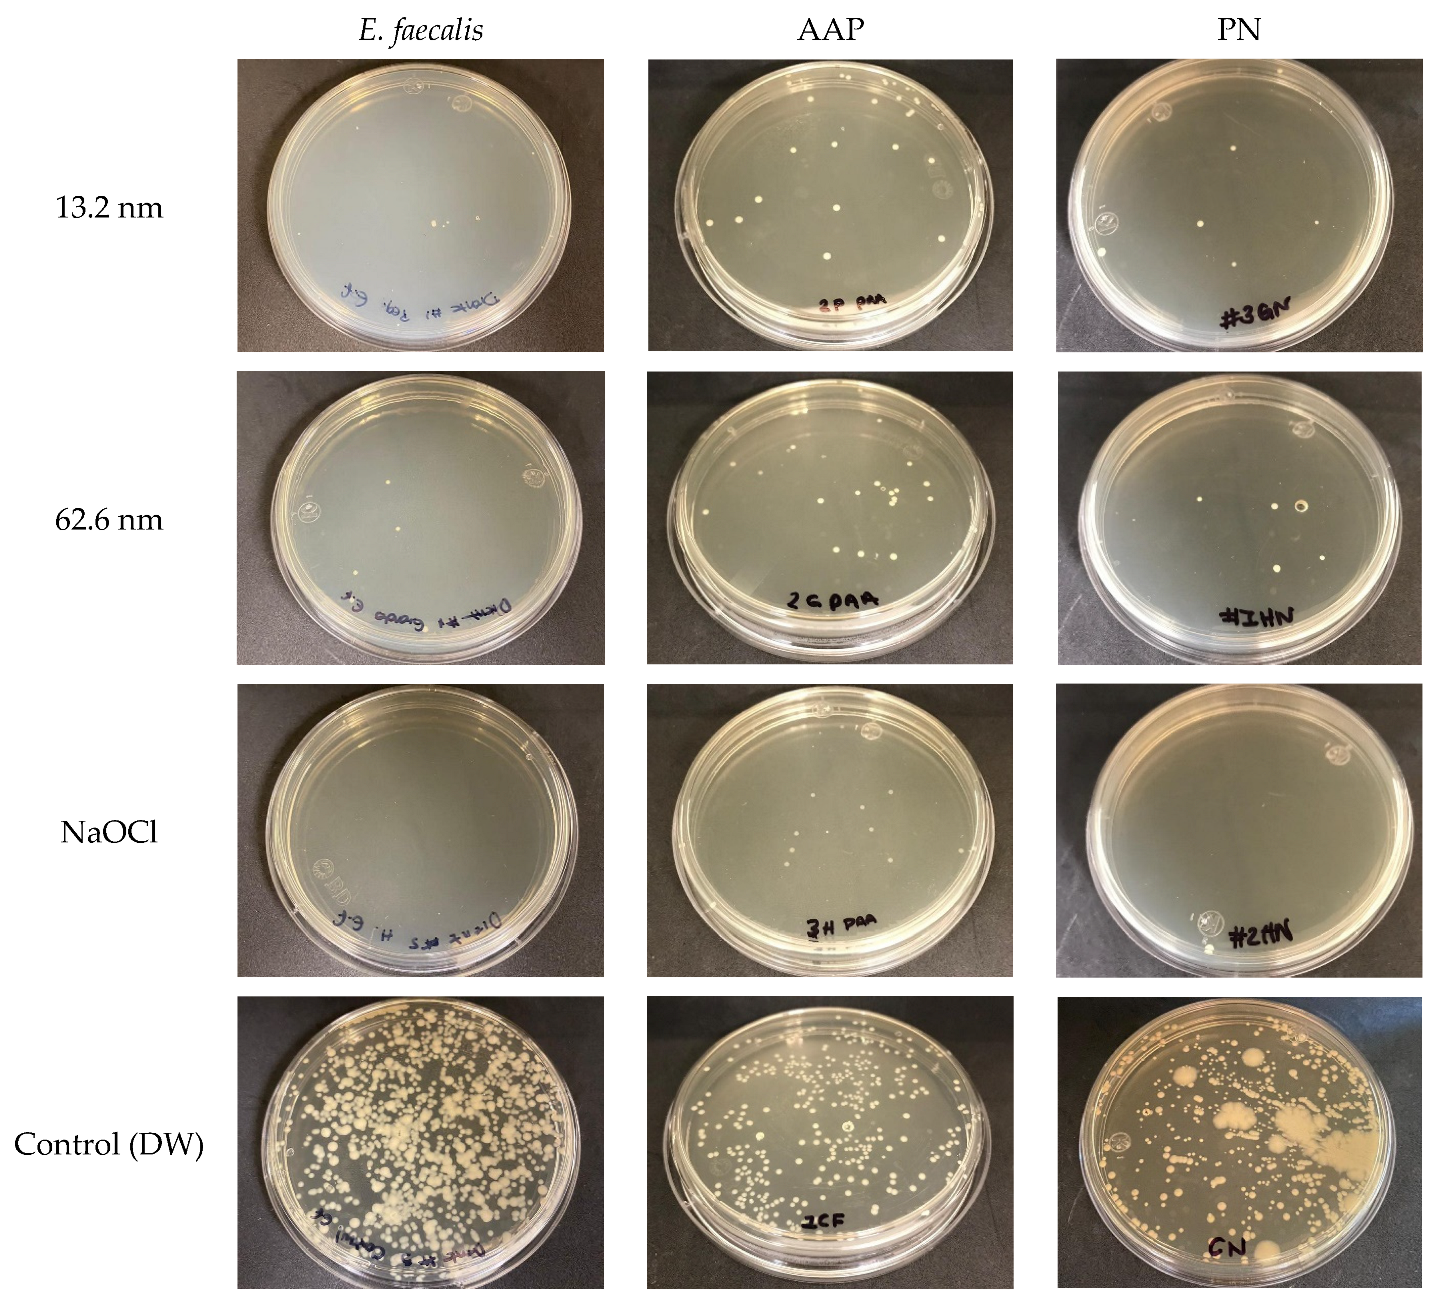
Pharmaceutics 17 00831 g006

Antibacterial and Anti-Adherence Efficacy of Silver Nanoparticles Against Endodontic Biofilms: An In Vitro and Ex Vivo Study
Abstract
1. Introduction
2. Materials and Methods
2.1. Preparation and Characterization of AgNPs
2.2. Collection of Endodontic Biofilms
2.3. Standardization of Bacterial Suspension
2.4. Antimicrobial Test of AgNPs on Oral Biofilms
2.5. Antimicrobial Substantivity of AgNPs
2.6. Anti-Adherence Activity of AgNPs in an Ex Vivo Model
2.7. Statistical Analysis
3. Results
3.1. Physical Characterization of AgNPs
3.2. Bactericidal Activity of AgNPs in Endodontic Biofilms
3.3. Antimicrobial Substantivity of AgNPs in Endodontic Biofilms
3.4. Anti-Adherence Activity of AgNPs in an Ex Vivo Model
4. Discussion
5. Conclusions
Author Contributions
Funding
Institutional Review Board Statement
Informed Consent Statement
Data Availability Statement
Acknowledgments
Conflicts of Interest
References
- Abusrewil, S.; Alshanta, O.A.; Albashaireh, K.; Alqahtani, S.; Nile, C.J.; Scott, J.A.; McLean, W. Detection, Treatment and Prevention of Endodontic Biofilm Infections: What’s New in 2020? Crit. Rev. Microbiol. 2020, 46, 194–212. [Google Scholar] [CrossRef] [PubMed]
- Yang, S.; Meng, X.; Zhen, Y.; Baima, Q.; Wang, Y.; Jiang, X.; Xu, Z. Strategies and Mechanisms Targeting Enterococcus faecalis Biofilms Associated with Endodontic Infections: A Comprehensive Review. Front. Cell. Infect. Microbiol. 2024, 14, 1433313. [Google Scholar] [CrossRef] [PubMed]
- Siqueira, J.F.; Rôças, I.N. Present Status and Future Directions: Microbiology of Endodontic Infections. Int. Endod. J. 2022, 55 (Suppl. S3), 512–530. [Google Scholar] [CrossRef] [PubMed]
- Neelakantan, P.; Romero, M.; Vera, J.; Daood, U.; Khan, A.U.; Yan, A.; Cheung, G.S.P. Biofilms in Endodontics-Current Status and Future Directions. Int. J. Mol. Sci. 2017, 18, 1748. [Google Scholar] [CrossRef]
- Markowska, K.; Grudniak, A.M.; Wolska, K.I. Silver Nanoparticles as an Alternative Strategy against Bacterial Biofilms. Acta Biochim. Pol. 2013, 60, 523–530. [Google Scholar] [CrossRef]
- Ricucci, D.; Siqueira, J.F. Biofilms and Apical Periodontitis: Study of Prevalence and Association with Clinical and Histopathologic Findings. J. Endod. 2010, 36, 1277–1288. [Google Scholar] [CrossRef]
- Rocha, C.T.; Rossi, M.A.; Leonardo, M.R.; Rocha, L.B.; Nelson-Filho, P.; Silva, L.A.B. Biofilm on the Apical Region of Roots in Primary Teeth with Vital and Necrotic Pulps with or without Radiographically Evident Apical Pathosis. Int. Endod. J. 2008, 41, 664–669. [Google Scholar] [CrossRef]
- Haapasalo, M.; Shen, Y.; Wang, Z.; Gao, Y. Irrigation in Endodontics. Br. Dent. J. 2014, 216, 299–303. [Google Scholar] [CrossRef]
- Xu, H.; Ye, Z.; Zhang, A.; Lin, F.; Fu, J.; Fok, A.S.L. Effects of Concentration of Sodium Hypochlorite as an Endodontic Irrigant on the Mechanical and Structural Properties of Root Dentine: A Laboratory Study. Int. Endod. J. 2022, 55, 1091–1102. [Google Scholar] [CrossRef]
- Nallapareddy, S.R.; Murray, B.E. Role Played by Serum, a Biological Cue, in the Adherence of Enterococcus faecalis to Extracellular Matrix Proteins, Collagen, Fibrinogen, and Fibronectin. J. Infect. Dis. 2008, 197, 1728–1736. [Google Scholar] [CrossRef]
- Herrera-Hidalgo, L.; Fernández-Rubio, B.; Luque-Márquez, R.; López-Cortés, L.E.; Gil-Navarro, M.V.; de Alarcón, A. Treatment of Enterococcus faecalis Infective Endocarditis: A Continuing Challenge. Antibiotics 2023, 12, 704. [Google Scholar] [CrossRef] [PubMed]
- Li, M.; Yang, F.; Lu, Y.; Huang, W. Identification of Enterococcus faecalis in a Patient with Urinary-Tract Infection Based on Metagenomic next-Generation Sequencing: A Case Report. BMC Infect. Dis. 2020, 20, 467. [Google Scholar] [CrossRef]
- Ch’ng, J.-H.; Muthu, M.; Chong, K.K.L.; Wong, J.J.; Tan, C.A.Z.; Koh, Z.J.S.; Lopez, D.; Matysik, A.; Nair, Z.J.; Barkham, T.; et al. Heme Cross-Feeding Can Augment Staphylococcus aureus and Enterococcus faecalis Dual Species Biofilms. Int. Soc. Microb. Ecol. J. 2022, 16, 2015–2026. [Google Scholar] [CrossRef]
- Șchiopu, P.; Toc, D.A.; Colosi, I.A.; Costache, C.; Ruospo, G.; Berar, G.; Gălbău, Ș.-G.; Ghilea, A.C.; Botan, A.; Pană, A.-G.; et al. An Overview of the Factors Involved in Biofilm Production by the Enterococcus Genus. Int. J. Mol. Sci. 2023, 24, 11577. [Google Scholar] [CrossRef]
- Haapasalo, M.; Endal, U.; Zandi, H.; Coil, J.M. Eradication of Endodontic Infection by Instrumentation and Irrigation Solutions. Endod. Top. 2005, 10, 77–102. [Google Scholar] [CrossRef]
- Flores, A.C.; Reyes, H.F.; Moscoso, A.G.; Castanedo Cázares, J.P.; Pozos Guillén, A. de Clinical Efficacy of 5% Sodium Hypochlorite for Removal of Stains Caused by Dental Fluorosis. J. Clin. Pediatr. Dent. 2009, 33, 187–192. [Google Scholar] [CrossRef]
- Wu, D.; Fan, W.; Kishen, A.; Gutmann, J.L.; Fan, B. Evaluation of the Antibacterial Efficacy of Silver Nanoparticles against Enterococcus faecalis Biofilm. J. Endod. 2014, 40, 285–290. [Google Scholar] [CrossRef]
- Slaughter, R.J.; Watts, M.; Vale, J.A.; Grieve, J.R.; Schep, L.J. The Clinical Toxicology of Sodium Hypochlorite. Clin. Toxicol. 2019, 57, 303–311. [Google Scholar] [CrossRef]
- Seredin, P.; Goloshchapov, D.; Peshkov, Y.; Potapov, A.; Gribanova, Y.; Shikhaliev, K.; Ippolitov, Y.; Freitas, R.O.; Mahdy, I.A.; Mahdy, M.A.; et al. Biomimetic Organomineral Layers with Antibacterial Properties Based on Di/Tetrahydroquinolinediol and Nanocrystalline Hydroxyapatite Deposited on Enamel Surface. Biomater. Sci. 2025, 13, 2444–2461. [Google Scholar] [CrossRef]
- Seredin, P.; Goloshchapov, D.; Litvinova, T. Biomaterials and Agents: Pharmaceutical and Biomedical Applications in Dental Research. Pharmaceutics 2024, 16, 894. [Google Scholar] [CrossRef]
- Kim, J.S.; Kuk, E.; Yu, K.N.; Kim, J.H.; Park, S.J.; Lee, H.J.; Kim, S.H.; Park, Y.K.; Park, Y.H.; Hwang, C.Y.; et al. Antimicrobial Effects of Silver Nanoparticles. Nanomed. Nanotechnol. Biol. Med. 2007, 3, 95–101. [Google Scholar] [CrossRef] [PubMed]
- Nizami, M.Z.I.; Xu, V.W.; Yin, I.X.; Yu, O.Y.; Chu, C.-H. Metal and Metal Oxide Nanoparticles in Caries Prevention: A Review. Nanomaterials 2021, 11, 3446. [Google Scholar] [CrossRef] [PubMed]
- Allaker, R.P. The Use of Nanoparticles to Control Oral Biofilm Formation. J. Dent. Res. 2010, 89, 1175–1186. [Google Scholar] [CrossRef] [PubMed]
- Hernández-Venegas, P.A.; Martínez-Martínez, R.E.; Zaragoza-Contreras, E.A.; Domínguez-Pérez, R.A.; Reyes-López, S.Y.; Donohue-Cornejo, A.; Cuevas-González, J.C.; Molina-Frechero, N.; Espinosa-Cristóbal, L.F. Bactericidal Activity of Silver Nanoparticles on Oral Biofilms Related to Patients with and without Periodontal Disease. J. Funct. Biomater. 2023, 14, 311. [Google Scholar] [CrossRef]
- Pérez-Tanoira, R.; Fernández-Arias, M.; Potel, C.; Carballo-Fernández, R.; Pérez-Castro, S.; Boutinguiza, M.; Górgolas, M.; Lusquiños, F.; Pou, J. Silver Nanoparticles Produced by Laser Ablation and Re-Irradiation Are Effective Preventing Peri-Implantitis Multispecies Biofilm Formation. Int. J. Mol. Sci. 2022, 23, 12027. [Google Scholar] [CrossRef]
- Chávez-Andrade, G.M.; Tanomaru-Filho, M.; Basso Bernardi, M.I.; de Toledo Leonardo, R.; Faria, G.; Guerreiro-Tanomaru, J.M. Antimicrobial and Biofilm Anti-Adhesion Activities of Silver Nanoparticles and Farnesol against Endodontic Microorganisms for Possible Application in Root Canal Treatment. Arch. Oral Biol. 2019, 107, 104481. [Google Scholar] [CrossRef]
- Bahador, A.; Ayatollahi, B.; Akhavan, A.; Pourhajibagher, M.; Kharazifard, M.J.; Sodagar, A. Antimicrobial Efficacy of Silver Nanoparticles Incorporated in an Orthodontic Adhesive: An Animal Study. Front. Dent. 2020, 17, 14. [Google Scholar] [CrossRef]
- Espinosa-Cristóbal, L.F.; Holguín-Meráz, C.; Zaragoza-Contreras, E.A.; Martínez-Martínez, R.E.; Donohue-Cornejo, A.; Loyola-Rodríguez, J.P.; Cuevas-González, J.C.; Reyes-López, S.Y. Antimicrobial and Substantivity Properties of Silver Nanoparticles against Oral Microbiomes Clinically Isolated from Young and Young-Adult Patients. J. Nanomater. 2019, 2019, 3205971. [Google Scholar] [CrossRef]
- Chandra, S.S.; Miglani, R.; Srinivasan, M.R.; Indira, R. Antifungal Efficacy of 5.25% Sodium Hypochlorite, 2% Chlorhexidine Gluconate, and 17% EDTA With and Without an Antifungal Agent. J. Endod. 2010, 36, 675–678. [Google Scholar] [CrossRef]
- Vanitha, G.; Rajavel, K.; Boopathy, G.; Veeravazhuthi, V.; Neelamegam, P. Physiochemical Charge Stabilization of Silver Nanoparticles and Its Antibacterial Applications. Chem. Phys. Lett. 2017, 669, 71–79. [Google Scholar] [CrossRef]
- Miao, N.; Jiang, T.; Li, Y.; Xue, S.; Hao, S.; Zhou, C.; Gu, Y.; Li, R.; Yu, B.; Duan, X.; et al. Recombinant Keratin-Chitosan Cryogel Decorated with Gallic Acid-Reduced Silver Nanoparticles for Wound Healing. Int. J. Nanomed. 2024, 19, 10369–10385. [Google Scholar] [CrossRef] [PubMed]
- Mohamady Hussein, M.A.; Alamri, E.S.; Bayomy, H.M.; Albalawi, A.N.; Grinholc, M.; Muhammed, M. Developing Novel Hybrid Bilayer Nanofibers Based on Polylactic Acid with Impregnation of Chamomile Essential Oil and Gallic Acid-Stabilized Silver Nanoparticles. Int. J. Biol. Macromol. 2024, 282, 137262. [Google Scholar] [CrossRef] [PubMed]
- Choińska, R.; Dąbrowska, K.; Świsłocka, R.; Lewandowski, W.; Świergiel, A.H. Antimicrobial Properties of Mandelic Acid, Gallic Acid and Their Derivatives. Mini Rev. Med. Chem. 2021, 21, 2544–2550. [Google Scholar] [CrossRef] [PubMed]
- Choubey, S.; Goyal, S.; Varughese, L.R.; Kumar, V.; Sharma, A.K.; Beniwal, V. Probing Gallic Acid for Its Broad Spectrum Applications. Mini Rev. Med. Chem. 2018, 18, 1283–1293. [Google Scholar] [CrossRef]
- Mahboob, T.; Nawaz, M.; de Lourdes Pereira, M.; Tian-Chye, T.; Samudi, C.; Sekaran, S.D.; Wiart, C.; Nissapatorn, V. PLGA Nanoparticles Loaded with Gallic Acid—A Constituent of Leea indica against Acanthamoeba triangularis. Sci. Rep. 2020, 10, 8954. [Google Scholar] [CrossRef]
- Martínez-Castañón, G.A.; Niño-Martínez, N.; Martínez-Gutierrez, F.; Martínez-Mendoza, J.R.; Ruiz, F. Synthesis and Antibacterial Activity of Silver Nanoparticles with Different Sizes. J. Nanoparticle Res. 2008, 10, 1343–1348. [Google Scholar] [CrossRef]
- Rodrigues, A.S.; Batista, J.G.S.; Rodrigues, M.Á.V.; Thipe, V.C.; Minarini, L.A.R.; Lopes, P.S.; Lugão, A.B. Advances in Silver Nanoparticles: A Comprehensive Review on Their Potential as Antimicrobial Agents and Their Mechanisms of Action Elucidated by Proteomics. Front. Microbiol. 2024, 15, 1440065. [Google Scholar] [CrossRef]
- Verduzco-Chavira, K.; Vallejo-Cardona, A.A.; González-Garibay, A.S.; Torres-González, O.R.; Sánchez-Hernández, I.M.; Flores-Fernández, J.M.; Padilla-Camberos, E. Antibacterial and Antibiofilm Activity of Chemically and Biologically Synthesized Silver Nanoparticles. Antibiotics 2023, 12, 1084. [Google Scholar] [CrossRef]
- Qing, Y.; Cheng, L.; Li, R.; Liu, G.; Zhang, Y.; Tang, X.; Wang, J.; Liu, H.; Qin, Y. Potential Antibacterial Mechanism of Silver Nanoparticles and the Optimization of Orthopedic Implants by Advanced Modification Technologies. Int. J. Nanomed. 2018, 13, 3311–3327. [Google Scholar] [CrossRef]
- Sweet, M.J.; Chessher, A.; Singleton, I. Review: Metal-Based Nanoparticles; Size, Function, and Areas for Advancement in Applied Microbiology. Adv. Appl. Microbiol. 2012, 80, 113–142. [Google Scholar]
- May, A.; Kopecki, Z.; Carney, B.; Cowin, A. Practical Extended Use of Antimicrobial Silver (PExUS). ANZ J. Surg. 2022, 92, 1199–1205. [Google Scholar] [CrossRef] [PubMed]
- González-Luna, P.-I.; Martínez-Castañón, G.-A.; Zavala-Alonso, N.-V.; Patiño-Marin, N.; Niño-Martínez, N.; Morán-Martínez, J.; Ramírez-González, J.-H. Bactericide Effect of Silver Nanoparticles as a Final Irrigation Agent in Endodontics on Enterococcus faecalis: An Ex Vivo Study. J. Nanomater. 2016, 2016, 7597295. [Google Scholar] [CrossRef]
- Tülü, G.; Kaya, B.Ü.; Çetin, E.S.; Köle, M. Antibacterial Effect of Silver Nanoparticles Mixed with Calcium Hydroxide or Chlorhexidine on Multispecies Biofilms. Odontology 2021, 109, 802–811. [Google Scholar] [CrossRef] [PubMed]
- Prabhu, S.; Poulose, E.K. Silver Nanoparticles: Mechanism of Antimicrobial Action, Synthesis, Medical Applications, and Toxicity Effects. Int. Nano Lett. 2012, 2, 1–10. [Google Scholar] [CrossRef]
- Yin, I.X.; Zhang, J.; Zhao, I.S.; Mei, M.L.; Li, Q.; Chu, C.H. The Antibacterial Mechanism of Silver Nanoparticles and Its Application in Dentistry. Int. J. Nanomed. 2020, 15, 2555–2562. [Google Scholar] [CrossRef]
- Mikhailova, E.O. Silver Nanoparticles: Mechanism of Action and Probable Bio-Application. J. Funct. Biomater. 2020, 11, 84. [Google Scholar] [CrossRef]
- Lee, W.; Kim, K.-J.; Lee, D.G. A Novel Mechanism for the Antibacterial Effect of Silver Nanoparticles on Escherichia coli. BioMetals 2014, 27, 1191–1201. [Google Scholar] [CrossRef]
- Feng, Q.L.; Wu, J.; Chen, G.Q.; Cui, F.Z.; Kim, T.N.; Kim, J.O. A Mechanistic Study of the Antibacterial Effect of Silver Ions on Escherichia coli and Staphylococcus aureus. J. Biomed. Mater. Res. 2000, 52, 662–668. [Google Scholar] [CrossRef]
- Bruna, T.; Maldonado-Bravo, F.; Jara, P.; Caro, N. Silver Nanoparticles and Their Antibacterial Applications. Int. J. Mol. Sci. 2021, 22, 7202. [Google Scholar] [CrossRef]
- De Celis, M.; Belda, I.; Marquina, D.; Santos, A. Phenotypic and Transcriptional Study of the Antimicrobial Activity of Silver and Zinc Oxide Nanoparticles on a Wastewater Biofilm-Forming Pseudomonas Aeruginosa Strain. Sci. Total Environ. 2022, 826, 153915. [Google Scholar] [CrossRef]
- Ershov, V.A.; Ershov, B.G. Effect of Silver Nanoparticle Size on Antibacterial Activity. Toxics 2024, 12, 801. [Google Scholar] [CrossRef] [PubMed]
- Ghorbanzadeh, A.; Bahador, A.; Sarraf, P.; Ayar, R.; Fekrazad, R.; Asefi, S. Ex Vivo Comparison of Antibacterial Efficacy of Conventional Chemomechanical Debridement Alone and in Combination with Light-Activated Disinfection and Laser Irradiation against Enterococcus faecalis Biofilm. Photodiagnosis Photodyn. Ther. 2020, 29, 101648. [Google Scholar] [CrossRef] [PubMed]
- Li, H.; Yang, Z.; Khan, S.A.; Walsh, L.J.; Seneviratne, C.J.; Ziora, Z.M. Characteristics of Metallic Nanoparticles (Especially Silver Nanoparticles) as Anti-Biofilm Agents. Antibiotics 2024, 13, 819. [Google Scholar] [CrossRef] [PubMed]
- Shannahan, J.H.; Podila, R.; Aldossari, A.A.; Emerson, H.; Powell, B.A.; Ke, P.C.; Rao, A.M.; Brown, J.M. Formation of a Protein Corona on Silver Nanoparticles Mediates Cellular Toxicity via Scavenger Receptors. Toxicol. Sci. 2015, 143, 136–146. [Google Scholar] [CrossRef]
- Raza, M.A.; Kanwal, Z.; Rauf, A.; Sabri, A.N.; Riaz, S.; Naseem, S. Size- and Shape-Dependent Antibacterial Studies of Silver Nanoparticles Synthesized by Wet Chemical Routes. Nanomaterials 2016, 6, 74. [Google Scholar] [CrossRef]
- Holguín-Meráz, C.; Martínez-Martínez, R.E.; Zaragoza-Contreras, E.A.; Domínguez-Pérez, R.A.; Reyes-López, S.Y.; Donohue-Cornejo, A.; Cuevas-González, J.C.; Silva-Benítez, E.d.L.; Molina-Frechero, N.; Espinosa-Cristóbal, L.F. Antibacterial Effect of Silver Nanoparticles against Oral Biofilms in Subjects with Motor and Intellectual Disabilities. J. Funct. Biomater. 2024, 15, 191. [Google Scholar] [CrossRef]
- Wong, K.K.Y.; Cheung, S.O.F.; Huang, L.; Niu, J.; Tao, C.; Ho, C.-M.; Che, C.-M.; Tam, P.K.H. Further Evidence of the Anti-Inflammatory Effects of Silver Nanoparticles. ChemMedChem 2009, 4, 1129–1135. [Google Scholar] [CrossRef]
- Carvalho-Silva, J.M.; Reis, A.C. Dos Anti-Inflammatory Action of Silver Nanoparticles in Vivo: Systematic Review and Meta-Analysis. Heliyon 2024, 10, e34564. [Google Scholar] [CrossRef]
- Durán, N.; Silveira, C.P.; Durán, M.; Martinez, D.S.T. Silver Nanoparticle Protein Corona and Toxicity: A Mini-Review. J. Nanobiotechnology 2015, 13, 55. [Google Scholar] [CrossRef]
- Xu, L.; Wang, Y.-Y.; Huang, J.; Chen, C.-Y.; Wang, Z.-X.; Xie, H. Silver Nanoparticles: Synthesis, Medical Applications and Biosafety. Theranostics 2020, 10, 8996–9031. [Google Scholar] [CrossRef]
- Dos Santos, C.A.; Seckler, M.M.; Ingle, A.P.; Gupta, I.; Galdiero, S.; Galdiero, M.; Gade, A.; Rai, M. Silver Nanoparticles: Therapeutical Uses, Toxicity, and Safety Issues. J. Pharm. Sci. 2014, 103, 1931–1944. [Google Scholar] [CrossRef] [PubMed]
- Munger, M.A.; Radwanski, P.; Hadlock, G.C.; Stoddard, G.; Shaaban, A.; Falconer, J.; Grainger, D.W.; Deering-Rice, C.E. In Vivo Human Time-Exposure Study of Orally Dosed Commercial Silver Nanoparticles. Nanomedicine 2014, 10, 1–9. [Google Scholar] [CrossRef] [PubMed]
- Galandáková, A.; Franková, J.; Ambrožová, N.; Habartová, K.; Pivodová, V.; Zálešák, B.; Šafářová, K.; Smékalová, M.; Ulrichová, J. Effects of Silver Nanoparticles on Human Dermal Fibroblasts and Epidermal Keratinocytes. Hum. Exp. Toxicol. 2016, 35, 946–957. [Google Scholar] [CrossRef]
- Halkai, K.; Mudda, J.; Shivanna, V.; Patil, V.; Rathod, V.; Halkai, R. Cytotoxicity Evaluation of Fungal-Derived Silver Nanoparticles on Human Gingival Fibroblast Cell Line: An in Vitro Study. J. Conserv. Dent. 2019, 22, 160. [Google Scholar] [CrossRef]
- Gernhardt, C.R.; Eppendorf, K.; Kozlowski, A.; Brandt, M. Toxicity of Concentrated Sodium Hypochlorite Used as an Endodontic Irrigant. Int. Endod. J. 2004, 37, 272–280. [Google Scholar] [CrossRef]
- Uğur Aydin, Z.; Akpinar, K.E.; Hepokur, C.; Erdönmez, D. Assessment of Toxicity and Oxidative DNA Damage of Sodium Hypochlorite, Chitosan and Propolis on Fibroblast Cells. Braz. Oral Res. 2018, 32, e119. [Google Scholar] [CrossRef]
- Abbaszadegan, A.; Nabavizadeh, M.; Gholami, A.; Aleyasin, Z.S.; Dorostkar, S.; Saliminasab, M.; Ghasemi, Y.; Hemmateenejad, B.; Sharghi, H. Positively Charged Imidazolium-Based Ionic Liquid-Protected Silver Nanoparticles: A Promising Disinfectant in Root Canal Treatment. Int. Endod. J. 2015, 48, 790–800. [Google Scholar] [CrossRef]
- Gomes-Filho, J.E.; Silva, F.O.; Watanabe, S.; Cintra, L.T.A.; Tendoro, K.V.; Dalto, L.G.; Pacanaro, S.V.; Lodi, C.S.; de Melo, F.F.F. Tissue Reaction to Silver Nanoparticles Dispersion as an Alternative Irrigating Solution. J. Endod. 2010, 36, 1698–1702. [Google Scholar] [CrossRef]
- Khan, S.S.; Mukherjee, A.; Chandrasekaran, N. Impact of Exopolysaccharides on the Stability of Silver Nanoparticles in Water. Water Res. 2011, 45, 5184–5190. [Google Scholar] [CrossRef]
- Habibullah, G.; Viktorova, J.; Ulbrich, P.; Ruml, T. Effect of the Physicochemical Changes in the Antimicrobial Durability of Green Synthesized Silver Nanoparticles during Their Long-Term Storage. RSC Adv. 2022, 12, 30386–30403. [Google Scholar] [CrossRef]
- Xia, Q.; Yang, L.; Hu, K.; Li, K.; Xiang, J.; Liu, G.; Wang, Y. Chromium Cross-Linking Based Immobilization of Silver Nanoparticle Coating on Leather Surface with Broad-Spectrum Antimicrobial Activity and Durability. ACS Appl. Mater. Interfaces 2019, 11, 2352–2363. [Google Scholar] [CrossRef] [PubMed]
- Hernández Medina, R.; Kutuzova, S.; Nielsen, K.N.; Johansen, J.; Hansen, L.H.; Nielsen, M.; Rasmussen, S. Machine Learning and Deep Learning Applications in Microbiome Research. ISME Commun. 2022, 2, 98. [Google Scholar] [CrossRef] [PubMed]
- Fan, S.; Qin, P.; Lu, J.; Wang, S.; Zhang, J.; Wang, Y.; Cheng, A.; Cao, Y.; Ding, W.; Zhang, W. Bioprospecting of Culturable Marine Biofilm Bacteria for Novel Antimicrobial Peptides. iMeta 2024, 3, e244. [Google Scholar] [CrossRef] [PubMed]

| AgNP (nm) | Diameter DLS (nm) | Shape | Initial Concentration (μg/mL) | Zeta Potential (mV) |
|---|---|---|---|---|
| 13.2 | 13.2 ± 0.4 | Spherical | 1070 | −62.5 ± 19.5 |
| 62.6 | 62.6 ± 14.9 | Spherical | 1070 | −72.0 ± 3.9 |
| Biofilm Strains | AgNP 13.2 nm | AgNP 62.6 nm | NaOCl (Ctrl+) | Deionized Water (Ctrl-) | p-Value |
|---|---|---|---|---|---|
| PN | 0.12 ± 0.12 | 0.12 ± 0.18 | 0.08 ± 0.15 | 0.12 ± 0.12 | 0.292 |
| AAP | 0.07 ± 0.1 | 0.07 ± 0.09 | 0.09 ± 0.12 | 0.12 ± 0.13 | 0.361 |
| E. faecalis | 0.11 ± 0.13 | 0.11 ± 0.14 | 0.12 ± 0.13 | 0.12 ± 0.16 | 0.939 |
| Total | 0.10 ± 0.13 | 0.10 ± 0.14 | 0.10 ± 0.13 | 0.12 ± 0.13 | 0.406 |
| p-Value | 0.376 | 0.689 | 0.141 | 0.678 | - |
Disclaimer/Publisher’s Note: The statements, opinions and data contained in all publications are solely those of the individual author(s) and contributor(s) and not of MDPI and/or the editor(s). MDPI and/or the editor(s) disclaim responsibility for any injury to people or property resulting from any ideas, methods, instructions or products referred to in the content. |
© 2025 by the authors. Licensee MDPI, Basel, Switzerland. This article is an open access article distributed under the terms and conditions of the Creative Commons Attribution (CC BY) license (https://creativecommons.org/licenses/by/4.0/).
Share and Cite
Pérez-Sáenz, M.G.; Martínez-Martínez, R.E.; Zaragoza-Contreras, E.A.; Domínguez-Pérez, R.A.; Reyes-López, S.Y.; Donohue-Cornejo, A.; Cuevas-González, J.C.; Tovar-Carrillo, K.L.; de Lourdes Silva-Benítez, E.; Ayala-Herrera, J.L.; et al. Antibacterial and Anti-Adherence Efficacy of Silver Nanoparticles Against Endodontic Biofilms: An In Vitro and Ex Vivo Study. Pharmaceutics 2025, 17, 831. https://doi.org/10.3390/pharmaceutics17070831
Pérez-Sáenz MG, Martínez-Martínez RE, Zaragoza-Contreras EA, Domínguez-Pérez RA, Reyes-López SY, Donohue-Cornejo A, Cuevas-González JC, Tovar-Carrillo KL, de Lourdes Silva-Benítez E, Ayala-Herrera JL, et al. Antibacterial and Anti-Adherence Efficacy of Silver Nanoparticles Against Endodontic Biofilms: An In Vitro and Ex Vivo Study. Pharmaceutics. 2025; 17(7):831. https://doi.org/10.3390/pharmaceutics17070831
Chicago/Turabian StylePérez-Sáenz, Mariana Goretti, Rita Elizabeth Martínez-Martínez, Erasto Armando Zaragoza-Contreras, Rubén Abraham Domínguez-Pérez, Simón Yobanny Reyes-López, Alejandro Donohue-Cornejo, Juan Carlos Cuevas-González, Karla Lizette Tovar-Carrillo, Erika de Lourdes Silva-Benítez, José Luis Ayala-Herrera, and et al. 2025. "Antibacterial and Anti-Adherence Efficacy of Silver Nanoparticles Against Endodontic Biofilms: An In Vitro and Ex Vivo Study" Pharmaceutics 17, no. 7: 831. https://doi.org/10.3390/pharmaceutics17070831
APA StylePérez-Sáenz, M. G., Martínez-Martínez, R. E., Zaragoza-Contreras, E. A., Domínguez-Pérez, R. A., Reyes-López, S. Y., Donohue-Cornejo, A., Cuevas-González, J. C., Tovar-Carrillo, K. L., de Lourdes Silva-Benítez, E., Ayala-Herrera, J. L., & Espinosa-Cristóbal, L. F. (2025). Antibacterial and Anti-Adherence Efficacy of Silver Nanoparticles Against Endodontic Biofilms: An In Vitro and Ex Vivo Study. Pharmaceutics, 17(7), 831. https://doi.org/10.3390/pharmaceutics17070831

